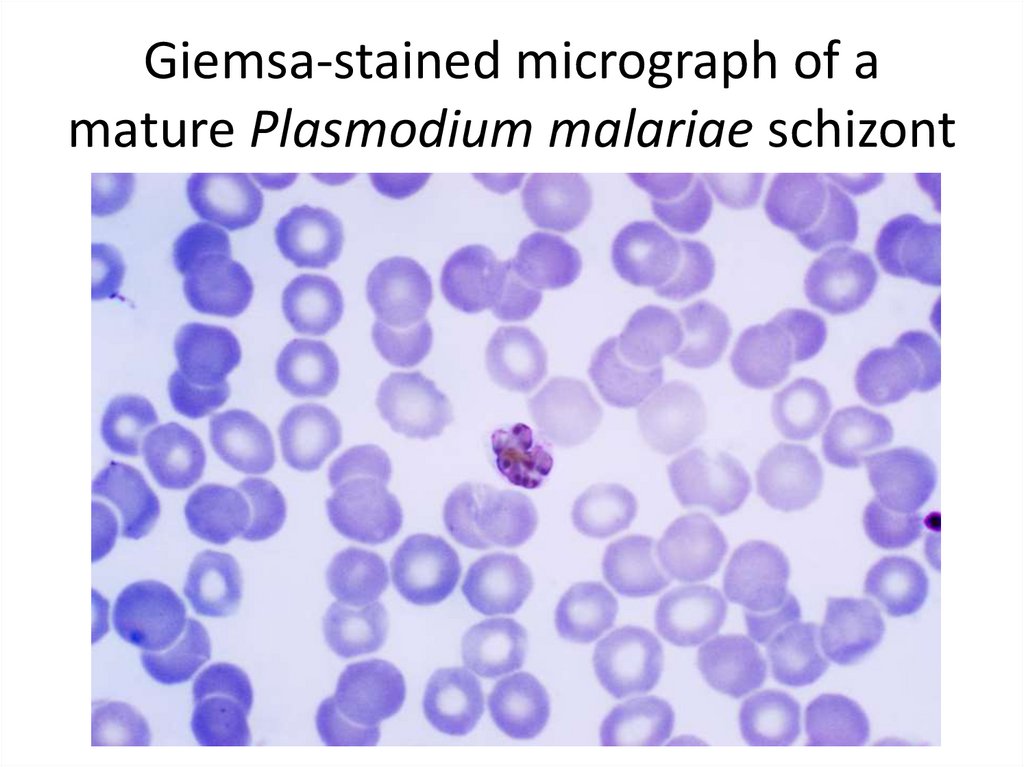

Похожие презентации:
Medical protozoology: Apicomplexa
1.
Medical protozoology:Apicomplexa
2.
3.
4.
5.
Diagram of T. gondii structure6.
DividingT. gondii
parasites
7.
T. gondii tissue cyst in a mouse brain, individualbradyzoites can be seen within
8.
9.
10.
11.
12.
13.
14.
15.
Distribution of malaria.16.
17.
Anopheles mosquito – definitive host ofPlasmodium.
18.
19.
20.
21.
22.
23.
Giemsa-stained micrograph of amature Plasmodium malariae schizont
24.
25.
26.
27.
28.
29.
30.
Lifecycle of
Babesia

Медицина
Медицина








